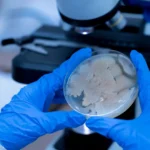

A elevação das duas entidades a essa condição ocorre no mesmo dia em que o presidente sancionou o ECA Digital. O projeto passou a ser conhecido como “PL da Adultização”, devido ao vídeo viral do youtuber Felca sobre exploração infantil na internet.
Agora, a lei entra em vigor dentro de seis meses —o Congresso Nacional determinou que o prazo seria de um ano, mas Lula vetou esse trecho. A lei terá regras para, entre outras coisas, obrigar plataformas digitais a verificar a idade dos usuários a fim de não destinar a crianças conteúdos feitos para adultos.
A ANPD será responsável por forçar as empresas a cumprir as normas. Por meio de medida provisória, o governo Lula transforma o órgão criado em 2019 para acompanhar a aplicação da LGPD (Lei Geral de Proteção de Dados) em uma espécie de “agência de serviços digitais”.
Vinculada ao Ministério da Justiça e Segurança Pública, a autoridade virou uma autarquia ainda em 2022, o que lhe conferiu mais autonomia e orçamento próprio. Absorver a nova função, porém, exigirá uma reestruturação em seu quadro de funcionários e no ordenamento interno.
Só depois dessa reorganização é que a ANPD editará exigências apenas previstas no ECA Digital, mas que carecem de normas.
Já o status do Cade como xerife das big techs ainda precisa ser avalizado pelo Congresso Nacional. Os novos poderes do conselho constam do Projeto de Lei dos Mercados Digitais, enviado aos parlamentares hoje pelo Executivo.

Deixe um comentário